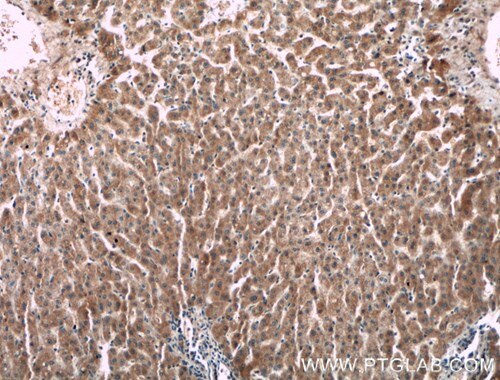
F2 antibody IHC in human liver tissue

How does blood coagulate?
Almost 1/10th of a human's body weight is made up of blood (male ±5.5 liters; female ±4.5 liters). Besides transporting oxygen and nutrients to our cells, blood plays a key role in our immune system and temperature homeostasis (1).
Summary
- Blood coagulation is a multi-step cascade that helps stop bleeding by turning liquid blood into a stable clot after injury.
- The process involves three linked pathways: the extrinsic pathway, the intrinsic pathway, and the common pathway.
- Both the intrinsic and extrinsic pathways lead to thrombin activation, which then converts fibrinogen into fibrin to form the clot.
- Human blood contains 13 coagulation factors, most of which are produced in the liver and work together to regulate clot formation.
- Problems with clotting factors can lead to bleeding disorders such as hemophilia A and B, where blood does not clot properly.
A few blood facts
- A single pint of donated blood can save 3 human beings.
- Blood is not always red.
- The human body has 100,000 kilometers of blood vessels running through it.
- Platelets, white blood cells, and red blood cells are suspended in plasma; a yellow liquid component of blood.
- Human blood contains atoms of metals, including a bit of gold.
- Red blood cells lack nuclei.
- There are 4 blood types that vary by population: A, B, AB, and O. Each blood type can be either RhD positive or RhD negative, giving a total of 8 main blood groups.
Blood clotting or coagulation – the blood coagulation cascade
Blood clotting is a multi-step process known as the blood coagulation cascade (2). The blood coagulation cascade is classified into three pathways—the extrinsic pathway, the intrinsic pathway, and the common pathway (Figure 1).

Figure 1. Blood coagulation cascade. Download the pathway poster here.
The extrinsic pathway is released by damaged cells and tissues. It is also known as the tissue factor pathway. The intrinsic pathway is a parallel pathway for thrombin activation by factor XII (Figure 2). It is triggered by blood encountering collagen fibers in the broken wall of a blood vessel. Both pathways eventually produce a prothrombin activator, triggering the common pathway in which prothrombin becomes thrombin followed by the conversion of fibrinogen to fibrin (3). It is important to note that this is a simplified description and research suggests that this process is much more complex. However, it is a useful approach for better understanding blood clotting.

Figure 2. Immunofluorescent analysis of (-20℃ Ethanol) fixed HepG2 cells using Factor XII antibody (66089-1-Ig) at a dilution of 1:100 and Alexa Fluor 488-conjugated AffiniPure Goat Anti-Mouse IgG(H+L).
13 blood coagulation factors
Our body activates coagulation factors that solidify blood into a clump by forming a special protein and fixing the clump at the wound. Humans have 13 clotting factors (4), the majority of which are produced in the liver (Table 1).
| Coagulation Factor | Common Name | Source | Pathway | Classification |
|---|---|---|---|---|
| Factor I | fibrinogen | liver | common | fibrinogen family |
| Factor II (Figure 3) |
prothrombin | liver | common | vitamin K dependent proteins |
| Factor III | tissue factor or thromboplastin | damaged tissue cells, platelets release thromboplastin | extrinsic | N/A |
| Factor IV | calcium ions | bone, and absorption through the lining of the small intestine | extrinsic, intrinsic, and common | N/A |
| Factor V (Figure 4) |
proaccelerin or labile factor | liver and platelets | N/A | fibrinogen family |
| Factor VI | accelerin, no longer used | N/A | common | N/A |
| Factor VII | proconvertin or stable factor | liver | extrinsic | vitamin K dependent proteins |
| Factor VIII (Figure 5) |
anti-hemophilic factor | platelets and the lining of blood vessels | intrinsic | fibrinogen family |
| Factor IX | plasma thromboplastin component / Christmas factor | liver | intrinsic | vitamin K dependent proteins |
| Factor X | Stuart Prower factor | liver | common | vitamin K dependent proteins |
| Factor XI | plasma thromboplastin antecedent | liver | intrinsic | contact family |
| Factor XII (Figure 6) |
Hageman factor | Liver | intrinsic | contact family |
| Factor XIII | fibrin stabilizing factor | liver | common | fibrinogen family |
Table 1. Clotting factors in the blood (N/A - not applicable).
Figure 3. Immunohistochemistry of paraffin-embedded human liver tissue slide using F2 antibody (66509-1-Ig) at a dilution of 1:150 (under 10x lens).
Figure 3. Immunohistochemistry of paraffin-embedded human liver tissue slide using F2 antibody (66509-1-Ig) at a dilution of 1:150 (under 10x lens).  Figure 4. Immunohistochemistry of paraffin-embedded human liver cancer tissue slide using F5 Antibody (20963-1-AP) at a dilution of 1:200 (under 40x lens).
Figure 4. Immunohistochemistry of paraffin-embedded human liver cancer tissue slide using F5 Antibody (20963-1-AP) at a dilution of 1:200 (under 40x lens).  Figure 5. Immunofluorescent analysis of (-20℃ Ethanol) fixed HUVEC cells using F8 antibody (21485-1-AP) at a dilution of 1:25 and Alexa Fluor 488-conjugated AffiniPure Goat Anti-Rabbit IgG(H+L).
Figure 5. Immunofluorescent analysis of (-20℃ Ethanol) fixed HUVEC cells using F8 antibody (21485-1-AP) at a dilution of 1:25 and Alexa Fluor 488-conjugated AffiniPure Goat Anti-Rabbit IgG(H+L).  Figure 6. Immunohistochemistry of paraffin-embedded human liver cancer tissue slide using Factor XIIIA antibody (66325-1-Ig) at a dilution of 1:400 (under 40x lens).
Figure 6. Immunohistochemistry of paraffin-embedded human liver cancer tissue slide using Factor XIIIA antibody (66325-1-Ig) at a dilution of 1:400 (under 40x lens).What if the blood does not clot well? Clotting disorders
Bleeding disorders occur when blood does not clot fast enough. Relatively common deficiencies of factors II, V, VII, X, and XII are related to blood clotting problems or abnormal bleeding problems. Hemophilia A and B are widely known clotting disorders. Blood does not clot correctly, which results in excess bruising and bleeding internally. The most common type is hemophilia A, which reflects a low level of clotting factor VIII, while hemophilia B displays a low level of factor IX (5, 6).
Closing remarks
A healthy body protects itself by clotting blood when injured, removing clots when they are no longer needed, and preventing clots from overgrowing. The entire blood coagulation process is a vital defense mechanism ensuring survival after tissue injury.
